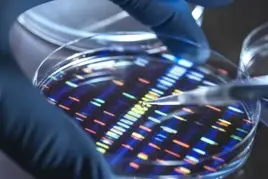
16818077030_TWI.webp

Dossier
Transmettre et hériter

© IRINA SCHMIDT/ADOB
Nous sommes tous des homo sapiens. Mais notre ADN n’a pas manqué d’être métissé, notamment par les gènes des Néandertaliens et autres dénisoviens… Aujourd’hui, les avancées de l’épigénétique confirment à quel point les données géographiques, historiques et sociales agissent sur l’expression de nos de nos gènes. Nous composons notre identité à partir de cet héritage à la fois génétique et culturel.
Qu’il soit matériel ou immatériel, l’héritage familial fait toujours l’objet de transformations. Les recettes de cuisine d’une grand-mère se retrouvent agrémentées des épices à la mode; les prénoms traditionnels laissent la place à ceux dans l’air du temps; quant aux choix politiques, les expériences personnelles remanient souvent les influences parentales. En matière de patrimoine, rien n’est simple!
Faut-il déboulonner les statues de ceux que l’on accuse de faits colonialistes ou racistes ? Peut-on s’approprier la culture de l’autre à travers des motifs vestimentaires, musicaux ou artistiques ? Les questions mémorielles ont investi le débat public et sont souvent sources de conflits. On s’aperçoit que la mémoire collective n’est jamais une donnée fixe, mais qu’elle se reconstruit en permanence

© IRINA SCHMIDT/ADOB